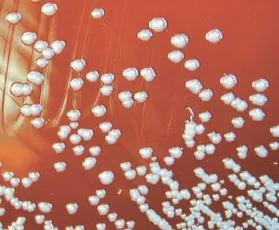

Бактерии спасают клопов от инсектицидов
Здравый смысл подсказывает нам, что устойчивость насекомых к химическим средствам борьбы с ними должна развиваться в течение не одного, а по меньшей мере нескольких поколений. При этом происходит отбор и наследование генов устойчивости в потомстве. Однако с клопами Riptortus pedestris всё иначе: у них резистентность к инсектицидам развивается в течение жизни одного поколения.
Происходит это, как установили японские энтомологи, благодаря присутствующим в их организмах бактериям рода Burkholderia. Публикация появилась в американском журнале PNAS (Proceedings of the National Academy of Sciences) [1]. Там сообщается, что данная бактерия делает клопов невосприимчивыми к инсектициду фенитротиону, традиционно применяемому на полях для защиты сои от этих вредителей. Чтобы проследить, какие симбиотические отношения связывают соевого клопа с бактериями, в лабораторных условиях был заложен опыт: клопы разводились на горшечной культуре, в почву которой вносились бактерии Burkholderia. Уже с личиночного возраста клопы начинали их потреблять, а позже поедали обработанные фенитротионом проростки сои. Исследуя кишечник, или, вернее сказать, кишечный канал насекомых, ученые обнаруживали в нем бактерии, численность которых со временем возрастала, а клопы при воздействии инсектицида не теряли жизнеспособность. Обычно при такой дозе фенитротиона 80 % клопов погибает.
Дальнейшие исследования показали, что в их кишечнике может скапливаться до 100 млн бактерий Burkholderia. Что характерно, такие клопы выглядят крупнее, чем их сородичи того же вида.
Нужно отметить, что развитие у вредителей резистентности к инсектицидам вызывает растущую обеспокоенность во всем мире. К счастью для японских фермеров, в естественных условиях обитания изучаемые бактерии не присутствуют в таких количествах и не потребляются соевыми клопами и их ближайшими «родственниками» — клопами-черепашками. Только у 8 % клопов были обнаружены бактерии рода Burkholderia, и то в одной лишь местности, и ни в какой другой. Поэтому очень немногие из них были способны развивать устойчивость к фенитротиону.
Исследователи отмечают, что такой симбиоз соевых клопов и бактерий, обезвреживающих инсектицид, был обнаружен впервые. Но раз уж этот факт установлен, то можно предполагать существование в природе и других подобных взаимосвязей. Кроме того, полученные данные свидетельствуют не только о развитии симбионт-опосредованной резистентности к инсектицидам в пределах одного поколения насекомых, но и о возможности горизонтальной передачи соответствующих способностей между различными насекомыми-вредителями и прочими организмами, обменивающимися бактериями.
Татьяна Борисова
1. www.pnas.org/content/early/2012/04/19/1200231109
2. http://phys.org/news/2012-04-bean-bugs-harbor-bacteria-safe.html